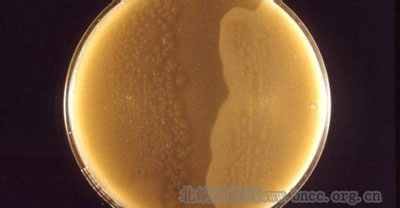
北纳创联产气荚膜梭菌

万千商家帮你免费找货
0 人在求购买到急需产品
- 详细信息
- 文献和实验
- 技术资料
- 保存条件:
真空冷冻干燥法
- 保质期:
1-2年
- 英文名:
Clostridium perfringens
- 供应商:
北纳生物
| 基本信息 | |
| 资源编号 | BNCC132249 |
| 资源名称 | 产气荚膜梭菌 |
| 种属 | Clostridium perfringens |
| 分离基物 | 病料 |
| 提供形式 | 冻干物 |
| 致病类型 | 食物中毒 |
| 安全等级 | 2 |
| 模式菌株 | no |
| 应用领域 | 科研、教学 |
| 培养方法 | |
| 培养基 | 52 |
| 生长条件 | 37 |
| 存储条件 | 真空冷冻干燥法; |
风险提示:丁香通仅作为第三方平台,为商家信息发布提供平台空间。用户咨询产品时请注意保护个人信息及财产安全,合理判断,谨慎选购商品,商家和用户对交易行为负责。对于医疗器械类产品,请先查证核实企业经营资质和医疗器械产品注册证情况。
文献和实验亦称威尔什菌。它是成为气坏疽主要病原的革兰氏阳性细菌,梭菌属的一个种。有的是食物中毒原因的菌种。威尔什( W. H. Welch)等所发现( 1892),非运动性,具有荚膜。在正常动物的肠内也有少量存在,有时因异常增殖而成为自体中毒症的原因。因具有侵入组织的特性,因而产生大量的粘朊酶而扩大脓疡。如有糖原则能进行酪酸发酵,但若给与蛋白质,则可对分解出的氨基酸进行非氧化的脱氨基反应,产生大量 NH3 , H2 和 CO2 ;另外可明显地使组氨酸脱羧而形成组胺。
产气荚膜梭菌( cl.perfringens) 是气性坏疽的主要病原菌。气性坏疽是战时多见的一种严重的创伤感染,以局部水肿、产气、肌肉坏死及全身中毒为特征。病原菌约有 6 ~ 9 种之多,常为混合感染。以产气荚膜梭菌为最多见(约占 60 ~ 90% ),其次是水肿梭菌和败毒棱菌,其他还有产芽胞梭菌、溶组织梭菌和双酶酸菌等。 为革兰氏阳性粗大梭菌, 3 ~ 4 × 1 ~ 1.5um 。单独或成双排列,有时也可成短链排列。芽胞呈卵圆形,芽胞宽度不比菌体
产气荚膜梭菌 产气荚膜梭菌为革兰阳菌粗短大杆菌,大小(1~1.5)μm×(3~5)μm.两端钝圆,单个或成双排列,偶见链状。芽胞椭圆形,位于菌体中央或次极端,芽胞直径不大于菌体,在一般培养时不易形成芽胞,在无糖培养基中有利于形成芽胞。在机体内可产生明显的荚膜,无鞭毛,不能运动。
技术资料暂无技术资料 索取技术资料